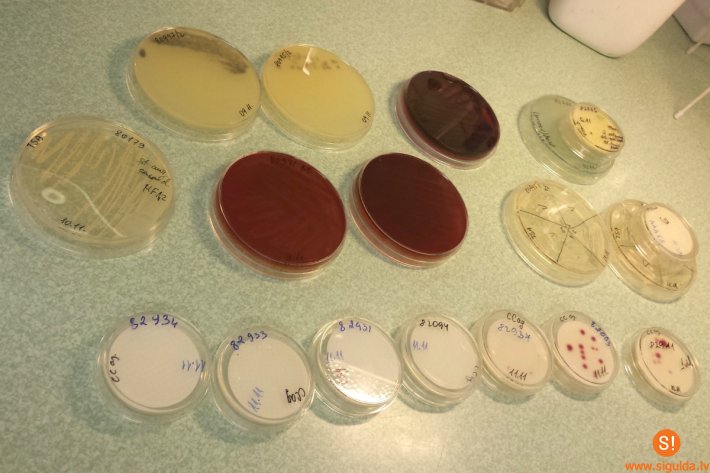

Ūdens ir mūsu dzīvības avots, tāpēc svarīgi ne tikai, cik daudz mēs dzeram, bet arī cik kvalitatīvu ūdeni lietojam ikdienā. Šoruden Latvijā ir neparasti sauss laiks un daudzās ūdens tilpnēs strauji krītas ūdens līmenis, tāpēc iedzīvotājus, kas lieto akas ūdeni un kā dzeramo ūdeni izmanto avotu ūdeni, satrauc jautājums – vai šādā situācijā nepasliktinās ūdens kvalitāte? Zinātniskā institūta „BIOR” Siguldas reģionālās laboratorijas vadītāja dr. sc. ing. Vita Strazdiņa atbild uz iedzīvotāju jautājumiem.
Vai avota ūdens ir vislabākais dzeršanai – vai tas ir tikai mīts?
Mūsdienās avota ūdens tiek atzīts par īpaši vērtīgu tieši savas izcelsmes dēļ. Vairums siguldiešu kā dzeramo ūdeni ikdienā lieto avota ūdeni, lai gan pēc bioloģiskajiem rādītājiem no krāna tekošais ūdens atbilst visiem valstī noteiktajiem normatīviem, tomēr izskata un ķīmiskā sastāva ziņā – kaļķainība, pārmērīgs dzelzs daudzums, nogulsnes un smarža, šis ūdens daudziem no mums nešķiet atbilstošs dzeršanai. Savukārt mūsu tik iecienītais avota ūdens pēc garšas un izskata šķiet piemērots ikdienas lietošanai, tomēr mēs nezinām tā mikrobioloģiskos rādītājus, līdz nav veiktas analīzes.
Daudzi domā: „Izrakšu savu aku – dzeršu tīrāku ūdeni”
Privāto aku un avota ūdeni mikrobioloģiski neviens neattīra, kā tas regulāri notiek ar ūdeni, kuru saņemam centralizēti. Tā kā privātmājām, kurās ir akas, parasti arvien vēl nav centralizētas notekūdeņu kanalizācijas, tad viens no akas ūdeņu ticamākajiem piesārņošanās iemesliem varētu būt netālu izvietoto notekūdeņu tvertņu satura nokļūšana aku gruntsūdeņos. Siguldā ir iedzīvotāji, kas, rūpējoties par savu un savas ģimenes veselību, reizēm veic personīgo aku ūdens pārbaudi, visbiežāk brīžos, kad bērniem parādās alerģijas – pirmā doma parasti ir, ka vainojams ūdens. Līdz ar to mikrobioloģisko analīžu veikšanai jābūt regulārai (īpaši pavasara un rudens sezonā), lai izvērtētu atbilstošu ūdens kvalitāti un drošumu lietošanai uzturā. Ja pēc analīžu veikšanas ūdens ir neatbilstošas kvalitātes, tad ir jāveic akas tīrīšana un dezinfekcija.
Kuri mikroorganismi padara ūdeni dzeršanai nederīgu?
Ūdens, ko siguldieši smeļ privātmāju akās vai atved savās kannās no avotiem, ko izmanto mājsaimniecībā, kas ir dzeramais ūdens, ir jābūt drošam un nekaitīgam cilvēka veselībai un tas nedrīkst saturēt tā saucamo patogēno mikrofloru: zarnu nūjiņu grupas baktērijas, tai skaitā Escherichia coli un zarnu enterokokus. Atbilstoši Ministru kabineta noteikumiem Nr.235 šo mikroorganismu skaitam ūdenī, ko lietojam uzturā ir jābūt – 0 koloniju veidojošās vienības uz 100 mililitriem ūdens. Bet ir pieļaujama ūdens dabīga, nekaitīga mikroflora līdz 100 koloniju veidojošam vienībām 1 mililitrā.
Mikroorganismi ūdenī nonāk galvenokārt no augsnes, dzīvnieku izkārnījumiem un to atliekvielām, cilvēku radītiem atkritumiem, tai skaitā notekūdeņiem, kā arī no gaisa.
Tā kā 2015.gadā avoti vēl arvien ir Siguldas novada iedzīvotāju un viesu iecienītas dzeramā ūdens ņemšanas vietas, arī šogad pēc Siguldas novada Domes pieprasījuma Pārtikas drošības, dzīvnieku veselības un vides zinātniskais institūta „BIOR” Siguldas laboratorija veica Siguldas apkārtnes iedzīvotāju apmeklētāko un iecienītāko avotu ūdens paraugu analīzes, lai noteiktu, vai šo avotu ūdens ir droši izmantojams pārtikā. Analīžu rezultāti liecina, ka avotos, kas ir visapmeklētākie, ir konstatēts vislielākais bakteriālais piesārņojums un ar gadiem tas neuzlabojas. Analīžu rezultāti ir apskatāmi šeit.
Cik bieži un kad vajadzētu veikt analīzes?
Analīžu veikšanas biežums atkarīgs no dažādiem faktoriem. Jāuzsver, ka avotu un aku ūdens mikrobioloģiskais fons (zarnu nūjiņu grupas baktērijas, enterokoku u.c. mikroorganismu klātbūtne) ir mainīgs, kas ir atkarīgs no daudziem faktoriem. Pavasarī, kad notiek sniega kušana, līdz ar sniega ūdeņiem no mazdārziņiem gruntsūdeņos, avotos un akās var ieplūst organiskā mēslojuma atliekas, līdz ar tām arī daudzi mikroorganismi. Vaļējās akas pilsētas teritorijā var būt visbīstamākās. Jo lielāka pilsētas apdzīvotība, jo lielāks gruntsūdeņu piesārņojums, tādēļ jebkuram grodu akas īpašniekam jāpārbauda akas stāvoklis un jāveic ūdens analīzes. Tas pats attiecas uz piemājas urbumiem (spice) 9 – 11 m.
Vai var uzticēties analīžu rezultātiem?
Zinātniskajam institūtam „BIOR” ir Baltijā lielākā laboratorija ar vairāk nekā 300 akreditētām laboratoriskās testēšanas metodēm, kur gadā tiek veiktas vairāk nekā 1000 000 dažāda veida ūdens, pārtikas un citas ar vides drošību saistītas analīzes. Institūts iemantojis ne tikai vietēja mēroga, bet arī starptautisku atzinību un uzticamību. Kas attiecas uz laboratoriju darbu – „BIOR” darbības pamatā ir: neatkarība, konfidencialitāte, profesionālisms.
Kā pareizi ņemt ūdens analīzes?
Ir ļoti svarīgi strikti ievērot paraugu ņemšanas nosacījumus un piegādes termiņus. To var darīt pats klients, iepriekš konsultējoties ar „BIOR” ekspertiem, taču Zinātniskā institūta „BIOR” eksperti nodrošina paraugu ņemšanu klientam vēlamajā objektā un to transportēšanu uz laboratoriju.
Pārtikas drošības, dzīvnieku veselības un vides zinātniskais institūta BIOR Siguldas laboratorija atrodas Institūta ielā 1. Paraugu pieņemšanas laiks: no pirmdienas līdz ceturtdienai plkst.8.30 – 15.00, piektdienās no plkst.8.30 līdz 14.00. Tālrunis informācijai un konsultācijām: 28627405; 67976320. Adrese: Institūta iela 1, Siguldas pagasts., Siguldas novads., LV 2150, e‑pasts bior@bior. lvsigulda@bior.lv.